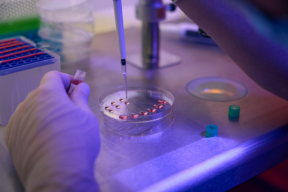

Le cellule di Hurthle possono essere presenti in diverse quantità in tutte le patologie benigne e maligne della tiroide dal gozzo alla tiroidite, dall’ adenoma follicolare al carcinoma papillifero.
Le lesioni a pattern follicolare costituite da cellule di Hurthle vengono classificate secondo gli stessi schemi utilizzati per le lesioni follicolari generiche (TIR 3).
STUDIO MEDICO DI CITOLOGIA AGOASPIRATIVA
La citologia agoaspirativa (nota anche come aspirazione con ago sottile, FNA – Fine Needle Aspiration) è una tecnica diagnostica utilizzata per prelevare campioni di cellule da un tessuto o da una massa per esaminarle al microscopio. Questo metodo è minimamente invasivo e viene comunemente impiegato per analizzare noduli o tumori sospetti, come quelli della tiroide, dei linfonodi, del seno, del fegato o di altre aree del corpo.